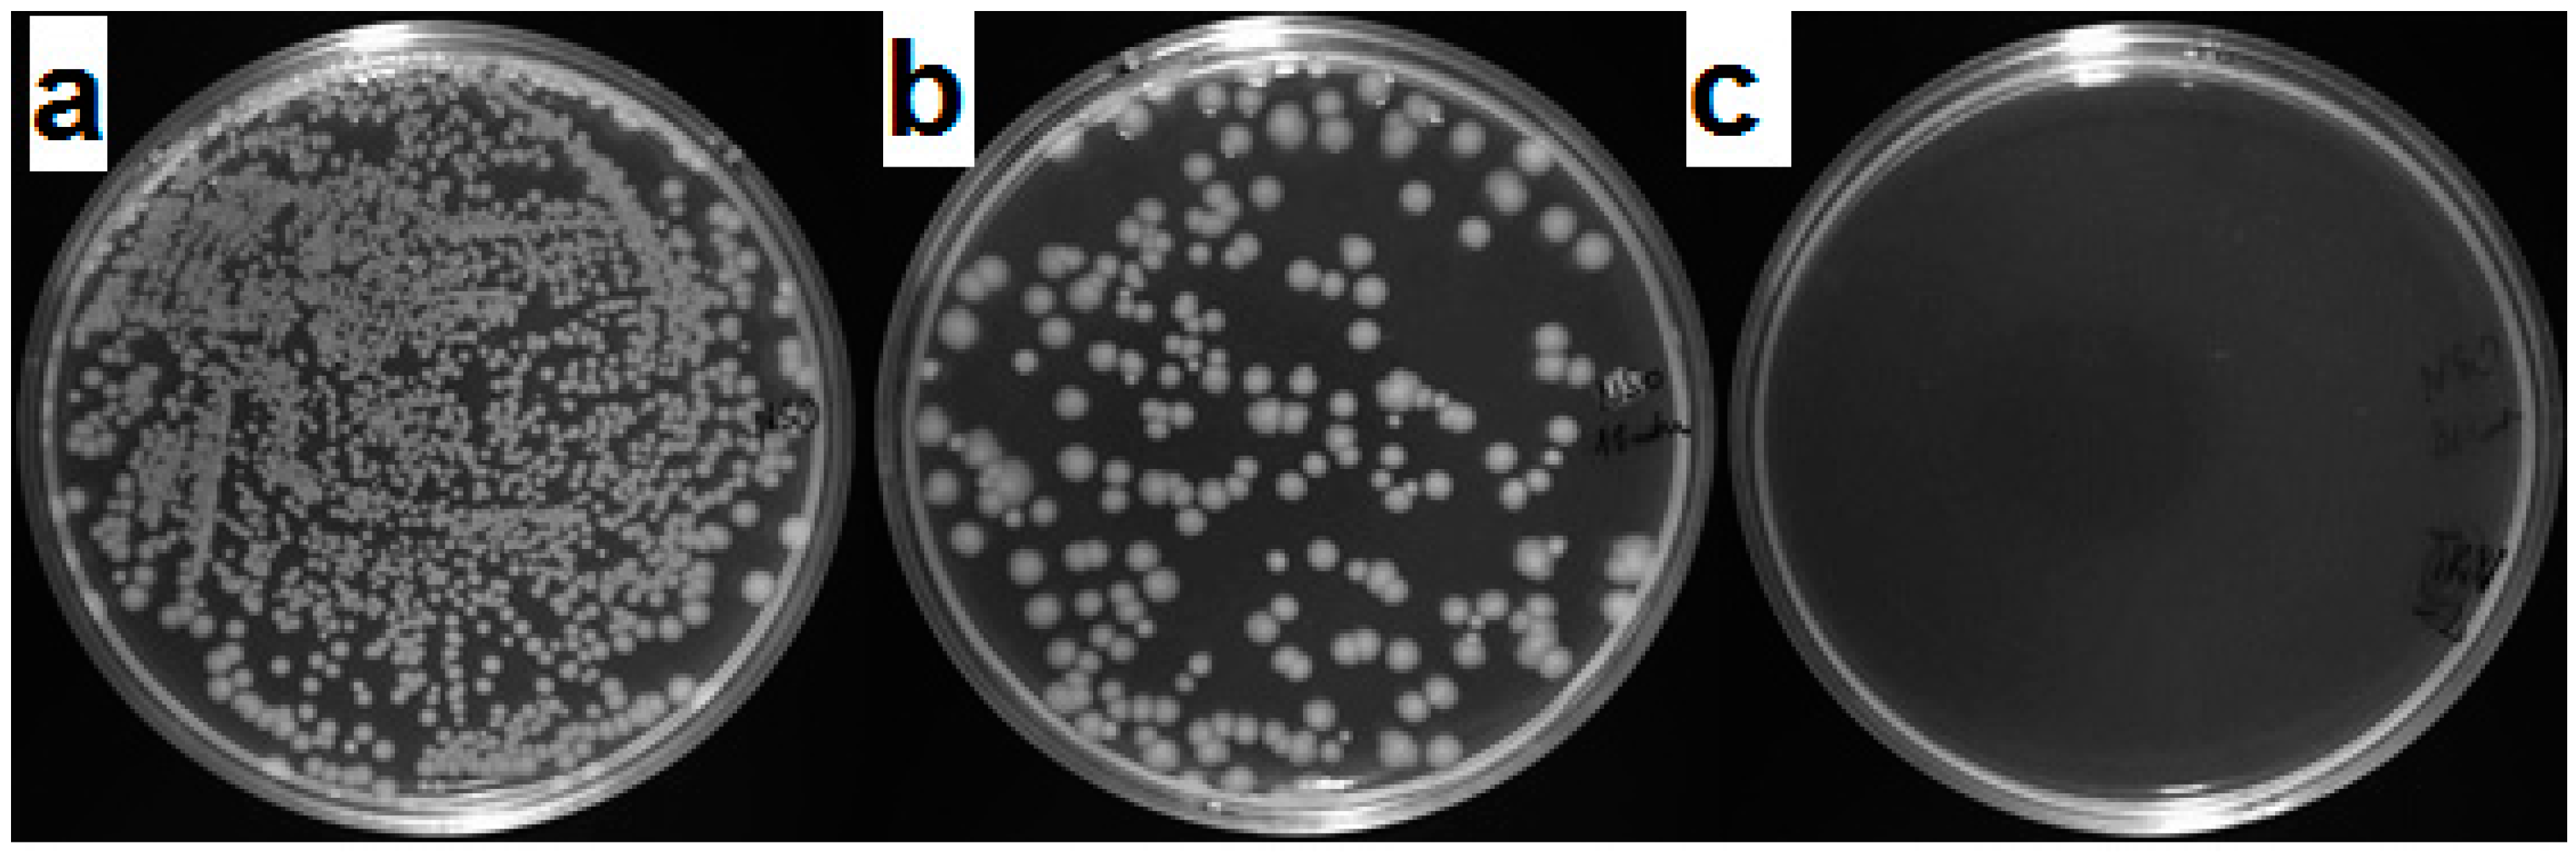
Materials 09 00701 g011

Characterization of Mechanical and Bactericidal Properties of Cement Mortars Containing Waste Glass Aggregate and Nanomaterials
Abstract
:1. Introduction
2. Materials and Methods
2.1. Materials
2.2. Cement Mortar Composition
2.3. Viability of Bacterial Cells after Contact with the Surface of the Mortar
3. Results and Discussion
3.1. Consistency
3.2. Flexural Strength
3.3. Compressive Strength
3.4. Water Absorption and Porosity
3.5. Bactericidal Properties
4. Conclusions
- Due to smooth impermeable surfaces of WG aggregate, the consistency of cement mortars is increased while compared to mortars containing quartz aggregate. However, poorer cohesion between the glass aggregates and cement paste (as a result of smoothness and grain shape of WG) contributes to flexural and compressive strength decrement.
- Presence of waste glass highly affects the microstructure of cement mortars by increasing the total porosity and water absorption of mortars, although this might cause higher efficiency in the inactivation of bacteria.
- Nanosilica due to its high pozzolanic activity and nanofiller effect improves the bond between the waste glass and the cement paste resulting in improving the final properties of cement mortars. In addition, nanosilica improves the microstructure of cement mortars by reducing the total porosity, refining the pore structure a decreasing water absorption of mortars. It was observed that sand can be successfully replaced with 100% of brown-soda waste glass (to obtain similar mechanical properties) while optimum amount of nanosilica is incorporated.
- Incorporation of waste glass as an aggregate in cement mortars containing cement modified with nanocrystalline titanium dioxide can improve the bactericidal properties of cement mortars against Gram-negative coliforms. Moreover, presence of nanosilica contributes to the pore structure refinement that increases the specific pore surface area, which is favorable for bacteria removal.
- Studied bacteria were inactivated in relatively short time (only 30 min), which is an advantage of the proposed mortar G100NS, because the shorter inactivation time is, the lower is the risk of spreading of bacteria in the environment.
Author Contributions
Conflicts of Interest
References
- Jani, Y.; Hogland, W. Waste glass in the production of cement and concrete—A review. J. Environ. Chem. Eng. 2014, 2, 1767–1775. [Google Scholar] [CrossRef]
- Bhandari, P.S.; Tajne, K.M. Use of waste glass in cement mortar. Int. J. Civ. Struct. Eng. 2013, 3, 704–711. [Google Scholar] [CrossRef]
- Degirmenci, N.; Yilmaz, A.; Cakir, O.A. Utilization of waste glass as sand replacement in cement mortar. Indian J. Eng. Mater. Sci. 2011, 18, 303–308. [Google Scholar]
- Terro, M.J. Properties of concrete made with recycled crushed glass at elevated temperatures. Build. Environ. 2006, 41, 633–639. [Google Scholar] [CrossRef]
- Ismail, Z.Z.; AL-Hashmi, E.A. Recycling of waste glass as a partial replacement for fine aggregate in concrete. Waste Manag. 2009, 29, 655–659. [Google Scholar] [CrossRef] [PubMed]
- Park, S.B.; Lee, B.C. Studies on expansion properties in mortar containing waste glass and fibers. Cem. Concr. Res. 2004, 34, 1145–1152. [Google Scholar] [CrossRef]
- Lee, G.; Poon, C.S.; Wong, Y.L. Effects of recycled fine glass aggregates on the properties of dry-mixed concrete blocks. Constr. Build. Mater. 2013, 38, 638–643. [Google Scholar] [CrossRef]
- Shi, C.; Zheng, K. Review on the use of waste glasses in the production of cement and concrete. Resour. Conserv. Recycl. 2007, 52, 234–247. [Google Scholar] [CrossRef]
- Topcu, I.B.; Canbaz, M. Properties of concrete containing waste glass. Cem. Concr. Res. 2004, 34, 267–274. [Google Scholar] [CrossRef]
- Penacho, P.; de Brito, J.; Rosário Veiga, M. Physico-mechanical and performance characterization of mortars incorporating fine glass waste aggregate. Cem. Concr. Compos. 2014, 50, 47–59. [Google Scholar] [CrossRef]
- Du, H.; Tan, K.H. Effect of particle size on alkali–silica reaction in recycled glass mortars. Constr. Build. Mater. 2014, 66, 275–285. [Google Scholar] [CrossRef]
- Xi, Y.; Li, Y.; Xie, Z.; Lee, J.S. Utilization of solid wastes (waste glass or rubber particles) as aggregate in concrete. In Proceedings of the International Workshop on Sustainable Development and Concrete Technology, Beijing, China, 20–21 May 2004.
- Liu, S.; Wang, S.; Tang, W.; Hu, N.; Wei, J. Inhibitory effect of waste glass powder on ASR expansion induced by waste glass aggregate. Materials 2015, 8, 6849–6862. [Google Scholar] [CrossRef]
- Ling, T.C.; Poon, C.S. A comparative study on the feasible use of recycled beverage and CRT funnel glass as fine aggregate in cement mortar. J. Clean. Prod. 2012, 29–30, 46–52. [Google Scholar] [CrossRef]
- Rashad, A.M. Recycled waste glass as fine aggregate replacement in cementitious materials based on Portland cement. Constr. Build. Mater. 2014, 72, 340–357. [Google Scholar] [CrossRef]
- Idir, R.; Cyr, M.; Tagnit-Hamou, A. Use of fine glass as ASR inhibitor in glass aggregate mortars. Constr. Build. Mater. 2010, 24, 1309–1312. [Google Scholar] [CrossRef]
- Du, H.; Tan, K.H. Concrete with recycled glass as fine aggregates. ACI Mater. J. 2014, 111, 47–58. [Google Scholar] [CrossRef]
- Aly, M.; Hashmi, M.S.J.; Olabi, A.G. Effect of colloidal nano-silica on the mechanical and physical behaviour of waste-glass cement mortar. Mater. Des. 2012, 33, 127–135. [Google Scholar] [CrossRef]
- Lackhoff, M.; Prieto, X.; Nestle, N.; Dehn, F.; Niessner, R. Photocatalytic activity of semiconductor-modified cement—Influence of semiconductor type and cement ageing. Appl. Catal. B 2003, 43, 205–216. [Google Scholar] [CrossRef]
- Essawy, A.A.; El Abd Aleem, S. Physico-mechanical properties, potent adsorptive and photocatalytic efficacies of sulfate resisting cement blends containing micro silica and nano-TiO2. Constr. Build. Mater. 2014, 52, 1–8. [Google Scholar] [CrossRef]
- Zhang, X.; Fujishima, A.; Jin, M.; Emeline, A.V.; Murakami, T. Double-layered TiO2–SiO2 nanostructured films with self-cleaning and antireflective property. J. Phys. Chem. B 2006, 110, 142–148. [Google Scholar] [CrossRef]
- Faustini, M.; Nicole, L.; Boissière, C.; Innocenzi, P.; Sanchez, C.; Grosso, D. Hydrophobic, antireflective, self-cleaning, and antifogging sol–gel coatings: An example of multifunctional nanostructured materials for photovoltaic cells. Chem. Mater. 2010, 22, 4406–4413. [Google Scholar] [CrossRef]
- Miao, L.; Su, L.F.; Tanemura, S.; Fisher, C.A.J.; Zhao, L.L.; Liang, Q.; Xue, G. Cost-effective nanoporous SiO2–TiO2 coatings on glass substrates with antireflective and self-cleaning properties. Appl. Energy 2013, 112, 1198–1205. [Google Scholar] [CrossRef]
- Li, F.; Li, Q.; Kim, H. Spray deposition of electrospun TiO2 nanoparticles with self-cleaning and transparent properties onto glass. Appl. Surf. Sci. 2013, 276, 390–396. [Google Scholar] [CrossRef]
- Surekha, K.; Sundararajan, S. Self-cleaning glass. In Anti-Abrasive Nanocoatings; Aliofkhazraei, M., Ed.; Woodhead Publishing: Amsterdam, The Netherlands, 2015; pp. 81–103. [Google Scholar]
- Chen, J.; Kou, S.C.; Poon, C.S. Photocatalytic cement-based materials: Comparison of nitrogen oxides and toluene removal potentials and evaluation of self-cleaning performance. Build. Environ. 2011, 46, 1827–1833. [Google Scholar] [CrossRef]
- Vittoriadiamanti, M.; Pedeferri, M.P. Concrete, mortar and plaster using titanium dioxide nanoparticles: Applications in pollution control, self-cleaning and photo sterilization. In Nanotechnology in Eco-Efficient Construction; Pacheco-Torgal, F., Diamanti, M.V., Nazari, A., Goran-Granqvist, C., Eds.; Woodhead Publishing: Cambridge, UK, 2013; pp. 299–326. ISBN 978-0-85709-544-2. [Google Scholar]
- Shen, W.G.; Zhang, C.; Li, Q.; Zhang, W.S.; Cao, L.; Ye, J.Y. Preparation of titanium dioxide nano particle modificed photocatalytic self-cleaning concrete. J. Clean. Prod. 2015, 87, 762–765. [Google Scholar] [CrossRef]
- Zhao, A.; Yang, J.; Yang, E.-H. Self-cleaning engineered cementitious composites. Cem. Concr. Compos. 2015, 64, 74–83. [Google Scholar] [CrossRef]
- Ltifi, M.; Guefrech, A.; Mounanga, P.; Khelidj, A. Experimental study of the effect of addition of nano-silica on the behaviour of cement mortars. Proc. Eng. 2011, 10, 900–905. [Google Scholar] [CrossRef]
- Nazari, A.; Riahi, S. The effects of SiO2 nanoparticles on physical and mechanical properties of high strength compacting concrete. Compos. Part B 2011, 42, 570–578. [Google Scholar] [CrossRef]
- Horszczaruk, E.; Mijowska, E.; Cendrowski, K.; Mijowska, S.; Sikora, P. Effect of incorporation route on dispersion of mesoporous silica nanospheres in cement mortar. Constr. Build. Mater. 2014, 66, 418–421. [Google Scholar] [CrossRef]
- Hou, P.K.; Kawashima, S.; Wang, K.J.; Corr, D.J.; Qian, J.S.; Shah, S.P. Effects of colloidal nanosilica on rheological and mechanical properties of fly ash–cement mortar. Cem. Concr. Compos. 2013, 35, 12–22. [Google Scholar] [CrossRef]
- Horszczaruk, E.; Mijowska, E.; Cendrowski, K.; Mijowska, S.; Sikora, P. The influence of nanosilica with different morphology on the mechanical properties of cement mortars. Cem. Lime Concr. 2013, 1, 24–32. [Google Scholar]
- De Muynck, W.; De Belie, N.; Verstraete, W. Antimicrobial mortar surfaces for the improvement of hygienic conditions. J. Appl. Microbiol. 2009, 108, 62–72. [Google Scholar] [CrossRef] [PubMed]
- Nguyen, Y.; Sperandio, V. Enterohemorrhagic E. coli (EHEC) pathogenesis. Front. Cell. Infect. Microbiol. 2012, 2, 90. [Google Scholar] [CrossRef] [PubMed]
- Peleg, A.Y.; Hooper, D.C. Hospital-acquired infections due to gram-negative bacteria. N. Engl. J. Med. 2010, 362, 1804–1813. [Google Scholar] [CrossRef] [PubMed]
- Guo, M.Z.; Ling, T.C.; Poon, C.S. TiO2-based self-compacting glass mortar: Comparison of photocatalytic nitrogen oxide removal and bacteria inactivation. Build. Environ. 2012, 53, 1–6. [Google Scholar] [CrossRef]
- Guo, M.Z.; Ling, T.C.; Poon, C.S. Nano-TiO2-based architectural mortar for NO removal and bacteria inactivation: Influence of coating and weathering conditions. Cem. Concr. Compos. 2013, 36, 101–108. [Google Scholar] [CrossRef]
- Park, S.B.; Lee, B.C.; Kim, J.H. Studies on mechanical properties of concrete containing waste glass aggregate. Cem. Concr. Res. 2004, 34, 2181–2182. [Google Scholar] [CrossRef]
- EN 197-1:2011 Cement. Composition, Specifications and Conformity Criteria for Common Cements; BSI Standards Publication: London, UK, 2011.
- EN 196-1:2005 Methods of Testing Cement. Determination of Strength; BSI Standards Publication: London, UK, 2005.
- EN 1015-3:1999 Methods of Test for Mortar for Masonry. Determination of Consistence of Fresh Mortar (by Flow Table); BSI Standards Publication: London, UK, 1999.
- Aligizaki, K.K. Pore Structure of Cement-Based Materials—Testing, Interpretation and Requirement; Taylor & Francis: New York, NY, USA, 2006. [Google Scholar]
- Cook, R.A.; Hover, K.C. Mercury porosimetry of hardened cement paste. Cem. Concr. Res. 1999, 29, 933–943. [Google Scholar] [CrossRef]
- Zhu, L.; Elguindi, J.; Rensing, C. Antimicrobial activity of different copper alloy surfaces against copper resistant and sensitive Salmonella enterica. Food Microbiol. 2012, 30, 303–310. [Google Scholar] [CrossRef] [PubMed]
- Zheng, K. Recycled glass concrete. In Eco-Efficient Concrete; Pacheco-Torgal, F., Jalali, S., Labrincha, J., Eds.; Woodhead Publishing: London, UK, 2013; pp. 241–270. [Google Scholar] [CrossRef]
- Limbachiya, M.C. Bulk engineering and durability properties of washed glass sand concrete. Constr. Build. Mater. 2009, 23, 1078–1083. [Google Scholar] [CrossRef]
- Ling, T.C.; Poon, C.S. Use of recycled CRT funnel glass as fine aggregate in dry-mixed concrete paving blocks. J. Clean. Prod. 2014, 68, 209–215. [Google Scholar] [CrossRef]
- Ali, E.E.; Al-Tersawy, S.H. Recycled glass as a partial replacement for fine aggregate in self compacting concrete. Constr. Build. Mater. 2012, 35, 785–791. [Google Scholar] [CrossRef]
- Ghafari, E.; Costa, H.; Júlio, E. The effect of nanosilica addition on flowability, strength and transport properties of ultra high performance concrete. Mater. Des. 2014, 59, 1–9. [Google Scholar] [CrossRef]
- Zeng, Q.; Li, K.; Fen-chong, T.; Dangla, P. Pore structure characterization of cement pastes blended with high-volume fly-ash. Cem. Concr. Res. 2012, 42, 194–204. [Google Scholar] [CrossRef]
- Metha, P.K.; Monterio, P.J.M. Concrete, Microstructure, Properties and Materials; McGraw-Hill: London, UK, 2006. [Google Scholar] [CrossRef]
- Chen, X.; Wu, S.; Zhou, J. Experimental study and analytical model for pore structure of hydrated cement paste. Appl. Clay Sci. 2014, 101, 159–167. [Google Scholar] [CrossRef]
- Neville, A.M. Properties of Concrete, 4th ed.; Prentice Hall/Pearson: Harlow, UK, 2002; pp. 537–576. [Google Scholar]
- Zhao, H. Influence of pore structure on compressive strength of cement mortar. Sci. World J. 2014, 1–12. [Google Scholar] [CrossRef] [PubMed]
- Quercia, G.; Spiesz, P.; Brouwers, H.J.H. Effects of nano-silica (NS) additions on durability of SCC mixtures. In Durability of Reinforced Concrete from Composition to Protection; Polder, R., Gulikers, J.J.W., Andrade, C., Eds.; Springer: Delft, The Netherlands, 2015; pp. 125–143. [Google Scholar] [CrossRef]
- Oltulu, M.; Sahin, R. Pore structure analysis of hardened cement mortars containing silica fume and different nano-powders. Constr. Build. Mater. 2014, 53, 658–664. [Google Scholar] [CrossRef]
- Chen, J.; Poon, C.-S. Photocatalytic activity of titanium dioxide modified concrete materials—Influence of utilizing recycled glass cullets as aggregates. J. Environ. Manag. 2009, 90, 3436–3442. [Google Scholar] [CrossRef] [PubMed]
- Van Lieshout, B.; Spiesz, P.; Brouwers, H.J.H. Application of waste glass in translucent and photocatalytic concrete. In Proceedings of the 18th International Conference on Building Materials (IBAUSIL 2012), Weimar, Germany, 12–15 September 2012.
- Poon, C.S.; Cheung, E. NO removal efficiency of photocatalytic paving blocks prepared with recycled materials. Constr. Build. Mater. 2007, 21, 1746–1753. [Google Scholar] [CrossRef]
- Verdier, T.; Coutand, M.; Bertron, A. Antibacterial activity of TiO2 photocatalyst alone or in coatings on E. coli: The influence of methodological aspects. Coatings 2014, 4, 670–686. [Google Scholar] [CrossRef]
- Wei, C.; Lin, W.Y. Bactericidal activity of TiO2 photocatalyst in aqueous media: Toward a solar-assisted water disinfection system. Environ. Sci. Technol. 1994, 28, 934–938. [Google Scholar] [CrossRef] [PubMed]

| TiO2 | SiO2 | Al2O3 | Fe2O3 | CaO | MgO | SO3 | Na2O | K2O | Cl− | LOI |
|---|---|---|---|---|---|---|---|---|---|---|
| 2.72 | 17.2 | 5.29 | 1.00 | 36.25 | 1.57 | 0.00 | 0.00 | 0.47 | 0.00 | 3.5 |
| Sieve Size (mm) | Mass (%) | |
|---|---|---|
| Passing | Retained | |
| 2.00 | 1.60 | 7 ± 5 |
| 1.60 | 1.00 | 33 ± 5 |
| 1.00 | 0.50 | 67 ± 5 |
| 0.50 | 0.16 | 87 ± 5 |
| 0.16 | 0.08 | 99 ± 1 |
| Sample Designation | Unit Weight (kg/m3) | Sand Replacement with WG (%) | |||
|---|---|---|---|---|---|
| Cem II/A-S 42.5 R with Nano-TiO2 | Water | Nanosilica Suspension | Sand | ||
| R | 519 | 257 | - | 1546 | 0 |
| G25 | 519 | 257 | - | 1159 | 25 |
| G50 | 519 | 257 | - | 773 | 50 |
| G75 | 519 | 257 | - | 773 | 75 |
| G100 | 519 | 257 | - | - | 100 |
| RNS | 519 | 195 | 78 | 1546 | 0 |
| G25NS | 519 | 195 | 78 | 1159 | 25 |
| G50NS | 519 | 195 | 78 | 773 | 50 |
| G75NS | 519 | 195 | 78 | 386 | 75 |
| G100NS | 519 | 195 | 78 | - | 100 |
| Sample Designation | Flexural Strength (MPa) | Compressive Strength (MPa) | ||||
|---|---|---|---|---|---|---|
| 2 Days | 7 Days | 28 Days | 2 Days | 7 Days | 28 Days | |
| R | 5.4 | 6.9 | 8.4 | 28.1 | 37.4 | 50.4 |
| G25 | 5.8 | 7.1 | 7.9 | 25 | 35.4 | 54.7 |
| G50 | 5.8 | 6.6 | 7.6 | 24.3 | 34.3 | 48 |
| G75 | 5.7 | 6.6 | 7.3 | 22.8 | 34.3 | 47.5 |
| G100 | 5.6 | 6.7 | 7.3 | 23 | 33.9 | 46.4 |
| RNS | 6.2 | 7.7 | 8.6 | 31.1 | 45.1 | 62.4 |
| G25NS | 5.9 | 7.4 | 8.3 | 25.6 | 43.3 | 59.2 |
| G50NS | 6.0 | 7.3 | 7.8 | 24.5 | 41.9 | 55.5 |
| G75NS | 5.9 | 7.3 | 7.8 | 23.7 | 41.4 | 52.3 |
| G100NS | 5.5 | 7.0 | 7.4 | 24.1 | 40.5 | 53.3 |
© 2016 by the authors; licensee MDPI, Basel, Switzerland. This article is an open access article distributed under the terms and conditions of the Creative Commons Attribution (CC-BY) license (http://creativecommons.org/licenses/by/4.0/).
Share and Cite
Sikora, P.; Augustyniak, A.; Cendrowski, K.; Horszczaruk, E.; Rucinska, T.; Nawrotek, P.; Mijowska, E. Characterization of Mechanical and Bactericidal Properties of Cement Mortars Containing Waste Glass Aggregate and Nanomaterials. Materials 2016, 9, 701. https://doi.org/10.3390/ma9080701
Sikora P, Augustyniak A, Cendrowski K, Horszczaruk E, Rucinska T, Nawrotek P, Mijowska E. Characterization of Mechanical and Bactericidal Properties of Cement Mortars Containing Waste Glass Aggregate and Nanomaterials. Materials. 2016; 9(8):701. https://doi.org/10.3390/ma9080701
Chicago/Turabian StyleSikora, Pawel, Adrian Augustyniak, Krzysztof Cendrowski, Elzbieta Horszczaruk, Teresa Rucinska, Pawel Nawrotek, and Ewa Mijowska. 2016. "Characterization of Mechanical and Bactericidal Properties of Cement Mortars Containing Waste Glass Aggregate and Nanomaterials" Materials 9, no. 8: 701. https://doi.org/10.3390/ma9080701
APA StyleSikora, P., Augustyniak, A., Cendrowski, K., Horszczaruk, E., Rucinska, T., Nawrotek, P., & Mijowska, E. (2016). Characterization of Mechanical and Bactericidal Properties of Cement Mortars Containing Waste Glass Aggregate and Nanomaterials. Materials, 9(8), 701. https://doi.org/10.3390/ma9080701

